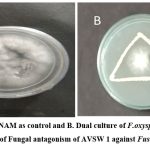

Introduction
Tomato (Lycopersicon esculentum Mill) is one of the rich source of vitamins, minerals, organic acids, essential amino acids and dietary fibres.Abiotic and Biotic factors(microbes) decreasing the production of tomato crop. Many Microbial diseases like Fusarium wilt, Early blight, Late blight, damping off, Leaf spots, Bacterial fruit canker, Anthracnose, bacterial speck affecting Tomato crop. Previous studies reports that ,soil nitrogen deficiency is decreasing quality and production of tomato crop, which can be reclaimed by potential PGP Bacteria as an alternative and eco friendly alternative to chemical fertilizers 1-5. Nowadays, bio inoculants have gained more global attention due to their eco-friendly, cost-effective and easily replicable nature and used in agricultural ecosystems because of the presence of plethora of secondary metabolites responsible for plant growth promotion ,stress tolerance and disease resistance 6-11. Endophytic bacteria enhances plant growth by the production of IAA, Ammonia, Siderophore, secondary metabolites, solubilizing Phosphate, increasing pathogenicity and maintain the integrity of host cell wall1,2,12,13. Due to its close association with the host, they developed a unique mechanism of synthesizing secondary metabolites for amicable association with the host in a symbiotic manner. Such specific secondary metabolites and volatile compounds express defence against fungi and bacteria ,induce systemic resistance, immunity and enhance plant growth under oxidative stress conditions14-19.
Siderophores produced by plant growth promoting bacteria are also involved in iron transportation and as biocontrol agents by scavenging the available iron present in the surroundings of the pathogen siderophore production 20. However, the metabolic profiling and physiological attributes of metabolites from endophytic bacteria have not been much focussed. The present research aimed to understand the metabolic profiling of an endophytic bacteria, Stenotrophomonas maltophilia isolate, extracted from green fruits of chilli and its physiological attributes in the growth promotion of tomato.
Isolation of Stenotrophomonas maltophila AVSW 1
AVSW 1 an endophytic bacteria isolated from the Green fruit of the chilli plant, was collected from Guntur, Andhra Pradesh, India . It was collected from the corresponding author as a subject for the current research.AVSW 1 was purified by the streak plate method and grown in nutrient broth. After 48 hrs of incubation, the endophytic bacterial strain was stored 21-23.
Materials and Methods
Screening of Fungal Antagonism and PGP Activities
The antifungal activity of AVSW 1 was assessed using the double culture method 24. Bacterial isolates were streaked on Sabouraud dextrose sugar (SDA) medium at 3 cm from the pathogenic fungi inoculated at the centre. Antifungal activity was measured at room temperature after 4-7 days of incubation. Inhibition levels were measured as I= 1-(a/b) X as described earlier13-17, 25,26.
Indole-3-acetic Acid Production
One ml culture filtrate of 72 hrs old bacterial culture was supplemented with 1 μg. ml– l L- tryptophan and 2 ml Salkowski reagent and incubated at 28 ± 20° C for 30 min. Appearance of Pink colour indicates the presence of IAA27.
Phosphate Solubilization
Solubilization of Tricalcium phosphate was detected in Pikovskaya’s agar 21. Bacterial isolate was streaked on the surface of the Pikovskaya agar medium, and activity was estimated after 1 to 5 days of incubation at room temperature. Development of the clear zone around the bacterial colony was a positive response for phosphate solubilization.
Ammonia Production
Fresh bacterial culture was inoculated into 10 ml of peptone water and incubated at 36 ± 2° C for 48-72 h.A change of colour from brown to yellow with the addition of 0.5 ml of Nessler’s reagent was a positive reaction for ammonia production 28.
Siderophore Production
The bacterial strain was grown on a succinate medium and incubated for 24-30 h with constant shaking at 120 rpm at 280 C. For every 20 minutes of interval, 5 ml broth was taken and centrifuged at 10,000 rpm for 10 min at 40 C. The cell-free supernatant was mixed with 0.5 ml CAS solution and colour was measured at 630 nm.0.5 ml un- inoculated succinate medium and 0.5 ml CAS solution was used as control 28.
Biochemical Physiological and Molecular Identification
Biochemical tests such as The IMViC test, Indole test, MRVP, Citrate utilization, hydrogen sulphide production, and sugar fermentation were done as per the standard protocols 29.
Physiological Characteristics
Amylase,Cellulase, Catalase, Oxidase,Urease, Gelatin hydrolysis, Nitrate reduction, Haemolysis and Lecithinase were analysed as per the protocols 29-32.
Molecular Identification
It was done according to Bergey’s manual of determinative bacteriology 33 for tentative identification of Genus followed by 16S rRNA partial gene sequencing analysis using universal primer 1492R (5´ TACGGYTACCTTGTTACGACTT-3′) and 27F (5′ AGAGTTTGATCMTGGCTCAG-3′). Phylogenetic tree analysis was done by using Neighbour joining method with 1000 bootstrap replicates. Isolate was deposited in GenBank, NCBI 34.
Optimization Studies
Physical parameters ,temperature, pH, incubation period, and chemical parameters NaCl, Carbon ,and nitrogen sources were studied in 10ml of broth inoculated with100 μl of bacterial culture and incubated for 48 h .O.D of the culture broth was read at 600 nm 35. Growth optimization of endophytic bacteria was analyzed at different temperatures ranging from 20-45°C at an interval of 5°C ,different pH value range [3-9] ,saline concentration range 1-6 % , 1% carbon sources ( Glucose, Fructose, Sucrose, Lactose, Maltose, Glycerol, Mannitol, Starch, and Cellulose), 0,5%nitrogen sources (KNO3, NaNO3, NH4SO2, Urea, Peptone, Beef extract, Yeast extract, Casein, and Malt extract) and incubation periods (24 h, 36 h, 48 h, 60 h and 72 h).Bacterial Growth Curve was also determined for 24 h bacterial culture at an interval of 4 h .
PGP Activity of Endophyte by Pot Assay Studies:
Tomato seeds were treated with 48 h bacterial culture for 30 min and shade-dried for 1 h. Inoculated seeds were seeded into coco peat,and the pots were kept under greenhouse conditions.% of seed germination was evaluated at an interval of 4,6 and 8 weeks. Physiological parameters, root length, shoot height ,biomass, no of leaves, no of lateral roots, and chemical constituents Protein content by Lowry’s and carbohydrate content by DNS method were estimated.
Metabolite profile Finger Print of Endophytic Bacteria
Secondary metabolite finger print of endophyte was analysed in ethyl acetate extract using Fourier transforms infrared spectroscopy (FTIR) and GC-MS36,37,39
Scanning Electron Microscopy
Root colonization ability was studied using SEM. One cm of root pieces were fixed and then processed with the PATOTO method. The prepared samples were mounted on aluminium stubs with Scotch TM double-sided tape, coated with gold in a sputtering Hummer II (Technics,Springfield,VA) and examined in a Cambridge S360 Scanning Electron Microscope.
Results and Discussion
Fungal Antagonism and PGP Traits
Pure culture of AVSW 1 was screened for fungal antagonism against Fusarium oxysporum by dual culture method as shown in Plate -1. AVSW 1 showed significant inhibition of Fusarium oxysporum compared to control and positive to PGP traits such as IAA, Ammonia, Phosphate solubilisation and siderophore production in qualitative screening.
![]() |
Plate 1: Screening of Fungal antagonism of AVSW 1 against Fusarium oxysporum. |
Effect of Physical and Chemical Parameters on Bacterial Growth:
Physicochemical parameters were analyzed on a one-time factor (OFOT) basis to optimize the growth and maximise the production of PGP traits. Optimization studies revealed that AVSW 1 showed maximum growth at 37 0 C, 1% salinity and 60 h incubation period with minimal medium ameliorated with 1% Fructose and 1 %Peptone (Fig 1).
The growth curve of S. maltophilia AVSW 1 showed 4-8 h of Lag phase,12-44 h of Exponential phase, and 44-68 h of stationary phase. After 68 h, the decline phase was observed (Fig2).
![]() |
Figure 1: Optimization of Physical and Chemical parameters on growth of AVSW 1. |
![]() |
Figure 2: Growth analysis of AVSW 1 from 4 – 96 h of incubation in optimized medium. |
PGP Traits of AVSW 1
Plant growth promotion (PGP) traits in S. maltophilia AVSW 1, such as IAA, Ammonia, PO4- solubilization and siderophore production, were evaluated after optimization.(Table1 and fig2 ) In S. maltophilia AVSW 1,IAA production increased by 55.66 % ,Ammonia production increased by 74.85 % ,Phosphate (po4– ) solubilization increased by 69.42 % and Siderophore production increased by 49.62 % after Optimization. Whereas in earlier findings, S. maltophilia JVB5, root endophyte of sunflower showed optimization were IAA (30.0 μg/ml) ,Phosphate solubilisation (32.23 ppm) and Siderophore (79.90 psu ) after optimization 4. Previous findings reported that two S.maltophila IPR-Pv696 and 262XG2 root nodular endophyte strains of clover reported IAA (30.26 μg /ml and 31.15 μg/ml), Phosphate solubilization (100 and 75%) and phosphate liberated (278 mg/l and 208 mg/l )11.10.73 μg /ml phosphate solubilization, Indole acetic acid 3.16 μg/ml and gibberellic Acid 40 μg /ml were observed in S. maltophilia , SBP-9 rhizobacteria of Sorghum bicolour at pH 8, temperature 30 0 C,Nacl Concentration 6 % and broth incubated for 48 h 6. 818 ppm Phosphate solubilisation, 1,62 IU /ml Acid phosphatase , 93µg/ml IAA production, Ammonia production (80 µg/ml) and ability to produce siderophore and HCN reported earlier in Stenotrophomonas maltophilia AVP 27 rhizobacterium of chilli 40. Similarly, present results also revealed that S.maltophila AVSW 1 is specific to the host in the expression of PGP traits and varies with endophytic and rhizospheric habitats. Further observed that the ability of phosphate solubilisation is less in endophytic strain compared to rhizosphere strain. It may be a marker characteristic feature to distinguish endophytic PGP strain from PGPR.
Table 1: Quantitative analysis of Plant growth promotion (PGP) traits in AVSW 1.
|
Optimization |
IAA (μg/ml) |
Ammonia (μg/ml) |
PO4– solubilization (ppm) |
Siderophore (psu) |
|
Before (control) |
14.17 |
15.07 |
33.6 |
33.33 |
|
After |
25.1 |
33.1 |
69.33 |
55.33 |
![]() |
Figure 3: Impact of optimization on Plant growth promotion (PGP) traits of AVSW 1 |
Identification of AVSW 1
Based on colony morphology, morphological, and physiological characteristics (Table 2) followed by 16s rRNA partial gene sequencing analysis (Fig 4), AVSW 1 was identified as Stenotrophomonas maltophilia and deposited in NCBI GENBANK with the name Stenotrophomonas maltophilia AVSW 1 with the accession no OQ293900
Table 2: Colony morphology and Morphological, Biochemical and physiological Characteristics of AVSW 1
|
Morphological Characteristics |
|
|
Colony Morphology |
Small, circular and off white |
|
Gram’s reaction |
Positive |
|
Cell shape |
Rod |
|
Biochemical Characteristics |
|
|
Indole ,MR |
Negative |
|
VP/Citrate |
positive |
|
Sugar fermentations |
|
|
Glucose /Sucrose/Fructose/Maltose/Mannitol |
A+/G– |
|
Lactose / Arabinose / Inositol / Sorbitol/Dulcitol |
A–/G– |
|
Physiological chaacteristics |
|
|
Decarboxylation reactions |
|
|
Ornithine/ Arginine / Creatinine/ Lysine |
Positive |
|
Malonate |
Negative |
|
Enzymatic reactions |
|
|
Amylase/Urease /Super oxide dismutase/ Phenylalanine deaminase /Gelatin hydrolysis/ Oxidase |
Negative |
|
Cellulase peroxidases Poly phenyl oxidase Lecithinase Catalase Oxidase Nitrate reduction |
positive |
|
Haemolysis |
Positive |
|
Spore formation |
Positive |
![]() |
Figure 4: Phylogenetic distance tree of Stenotrophomonas maltophilia AVSW 1 ( OQ293900) constructed by the neighbour-joining method using Blast N of NCBI with 1000 bootstraps |
Greenhouse Studies
The plant growth promotion potential of Stenotrophomonas maltophilia AVSW 1 was tested on tomato seedlings using the seed bacterization method followed by inoculation of culture at the collar region under greenhouse conditions. Root colonization efficacy of AVSW 1 inoculum was observed on 4, 6 and 8week old seedlings treated with AVSW 1 under scanning electron microscope (Fig 5.A & 5.B).
![]() |
Figure 5A: Scanning Electron Microgram of the root of tomato seedling treated with AVSW 1. |
![]() |
Figure 5B: Scanning Electron Microgram showing clear root Colonization in AVSW 1 treated tomato seedlings |
Growth parameters such as root length, shoot height, root shoot ratio, No of leaves and fresh weight, and nutritional metabolites (carbohydrates and proteins) were studied at intervals of two weeks from 4th week onwards using un inoculated tomato seedlings as control.
![]() |
Figure 6: Greenhouse studies of tomato seedlings treated with AVSW 1 |
In previous findings, endophytic bacterial strains, namely CT12, CT 13 and CT 16 of S. maltophilia isolated from fruit, stem and leaf of tomatoes, respectively, showed nearly 35.9 % enhancement of shoot height and 19.6-28.3% root length of tomato seedlings and also observed enhancement of fresh weight of shoot and root by 39.5 -57 % and 38.2 -58.8 % respectively under greenhouse conditions 41.
Similarly, Stenotrophomonas maltophilia BJ01 isolated from halo tolerant grass species showed a 17.68 % enhancement of shoot height and 57.14 % enhancement of fresh weight in peanut plants compared to control under high salt stress conditions (100 mM NaCl )9
In previous findings, Stenotrophomonas maltophilia SBP-9 rhizospheric isolate of Sorghum bicolour showed significant enhancement of 20 % shoot height, 28.81% root length, 28 % fresh weight and 42 % dry weight of the Plant and 18.40 % shoot fresh weight. It also reported that chlorophyll content increased by 55% at 150 mM NaCl, 39 % at 200 mM NaCl and 25 % at 200 mM NaCl when compared with 0 % NaCl in wheat plants 6.
S.maltophilia JVB5 isolated from sunflower root endosphere showed significant enhancement of root length ( 30.23 %), lateral roots (37.45 % ) and fresh weight (31.65%). IPR-Pv696 and 262XG2, two Bacillus toyonensis strains of root nodules of clover, showed a significant increase in fresh weight to (40.53 fed -1 and 42.68 tons fed -1), chlorophyll content by 4.51 % and carbohydrate content by 1.519 %, 20.18 % respectively 4 .
Similarly, in the present investigation, AVSW 1 treated tomato seedlings showed significant response in terms of the growth attributes and nutritive metabolites from the fourth week to the 8th (fig5.1 to 5.3). A significant increase of Shoot length (53.47 % ,41.85 % and 40.55 %) root length( 48.97 % , 48.76% and 52.97 %), number of leaves (92.29 %, 69.07 %, 84.33 %), lateral roots (52.81 %,43.77 %, 37.08 % ), fresh weight of Plant (90.10 %, 99.60 %, 81.6 %) in 4th, 6th and 8th weeks respectively in AVSW 1 treated plants compared to control (Fig 6 ). AVSW 1 treated plants also showed significant enhancement of protein and carbohydrate (66.66 %, 43.83 %, 45.75 % & 33.33 %, 33.96 %, 29.50 %) from 4th week to 8th week . Our results emphasized that the isolate AVSW 1 can promote plant growth and nutritional health and its antifungal activity against Fusarium oxysporum.
Based on the study, there is a significant increase in root and shoot length, number of leaves and lateral roots when compared withcontrol, protein and carbohydrate content and fresh weight is more in inoculated seeds and seeds treated with AVSW 1 inoculum showed better antifungal activity against Fusarium oxysporum .
![]() |
Figure 7A: Root length and shoot height on 4th ,6th and 8th week in treated and control plant |
![]() |
Figure 7B: Fresh weight and number of leaves on 4th, 6th and 8th week in treated and control plants. |
![]() |
Figure 7C: Lateral roots, Protein and carbohydrate on 4th, 6th and 8th week in treated and control |
![]() |
Figure 8: FTIR spectral analysis and interpretation of bioactive metabolites of Sphenotrophomonas maltophila AVSW1. |
Table 3: FTIR Spectral Data Analysis of Stenotrophomonas maltophila
|
Wavelength range |
Functional groups and their bonds |
|
3314.25 |
C-H stretch, Alkyne (strong, sharp) |
|
3303.73 |
OH stretch normal polymeric |
|
2944.98 |
C-H stretch, Alkane (medium) |
|
2832.35 |
N-H stretch, Alcohol (weak, broad) |
|
2042.92 |
N=C=N stretch, Isothiocyanate (strong) |
|
1659.67 |
C=C stretch, Alkene (medium) |
|
1449.21 |
C-H bend, Alkane (medium) |
|
1414.57 |
S=O stretch, Sulfate (strong) |
|
1114.16 |
C-O stretch, secondary alcohol (strong) |
|
1019.84 |
C-F stretch, Fluoro compound (strong) |
In GC MS chromatogram major peak was observed at 6 min 8sec with the retention factor value of 43.00 with the molecular weight of 42.9582g/mol with the chemical formula C6H12O2.Compared to the NIST library, the primary compound was identified as 2-pentanone, 4-hydroxy, 4-methyl ester, which is confirmed by the FTIR results. Similarly, the compounds identified in the GC-MS analysis are confirmed to be the same as those in the FTIR analysis. As per the results of GC-MS, the profile of the AVSW 1 extract contains volatile organic compounds and secondary metabolites, which can efficiently control phytopathogens, increase plant growth, and induce systemic resistance37-39.
![]() |
Figure 9: GC-MS analysis of metabolites of Stenotrophomonas maltophila AVSW1 at RT 6.30 GC-MS Chromatogram of Stenotrophomonas maltophila AVSW 1. |
Table 4: Metabolic Profile of Bacterial extract of AVSW 1 Stenotophomonas maltophilia
|
S.No |
RT |
Height |
Name of the compound |
Molecular Formula |
Mol wt |
Area % occupied |
Norm % |
|
1 |
6.830 |
30,461,028 |
2-Pentanone , 4-Hydroxy-4-Methyl- |
C6H12O2 |
116 |
20.389 |
100 |
|
3 |
19.990 |
44,1313,68 |
Cyclopropane,1-(1-Methyethyl)-2-Nonyl- |
C15H30 |
210 |
15.419 |
19.53 |
|
3 |
19.050 |
216,875,040 |
Glycine, N-Acetyl-N-(Trifluoro acetyl)-, Methyl Ester |
C7H8F3NO4 |
227 |
13.917 |
18.88 |
|
4 |
17.559 |
106,691,120 |
2-Acetoxy Iso butyryl Chloride |
C6H9O3Cl |
164 |
13.507 |
6.54 |
|
5 |
17.274 |
40,798,592 |
Propanoic Acid, 2-Oxo-, Methyl Ester |
C4H6O3 |
102 |
12.275 |
60.20 |
|
6 |
18.500 |
52,147,852 |
Pentanoic Acid, 4-Oxo- |
C5H8O3 |
116 |
7.883 |
66.24 |
|
7 |
7.395 |
20,769,012 |
2-Pentanone, 4-Hydroxy-4-Methyl- |
C6H12O2 |
116 |
3.983 |
38.66 |
|
8 |
7.660 |
15,587,187 |
2-Hexanone, 6-Acetyloxy) |
C8H14O3 |
158 |
3.849 |
16.79 |
|
9 |
18.640 |
35,413,672 |
5-Hydroxy pentane hydroxyl amine, N,O,OTriacetyl- |
C11H19O5n |
245 |
3.423 |
68.26 |
|
10 |
22.727 |
42,736,244 |
Ethanol, 2-(Octyloxy)- |
C10H22O2 |
174 |
2.664 |
6.66 |
|
11 |
19.330 |
24,171,646 |
2-yclopenten-1-One, 2-Hydroxy -3,4-Dimethyl- |
C7H10O2 |
126 |
1.357 |
75.62 |
|
12 |
16.194 |
13,718,134 |
2-Pentanone, 4-Hydroxy-4-Methyl- |
C6H12O2 |
116 |
1.333 |
13.06 |
![]() |
Figure 10: GC-MS spectrum of Active metabolites of Sphenotrophomonas matalopjila AVSW 1 at RT 6.830 |
Metabolic Profile of Bacterial Extract of AVSW 1 Stenotrophomonas maltophilia
As per the NIST Database, bioactive metabolites such as 2-Pentanone, 4-Hydroxy-4-methyl, Cyclopropane,1-(1-Methyl ethyl)-2-Nonyl-, Glycine, N-Acetyl-N-(Trifluoro acetyl)-, Methyl Ester, 2-Acetoxy Iso butyryl Chloride, Propanoic Acid, 2-Oxo-, Methyl Ester, Pentanoic Acid, 4-Oxo-,5-Hydroxypentanehydroxylamine, Ethanol, 2-(Octyloxy)-, 2-Cyclopenten-1-One, 2-Hydroxy-3,4-Dimethyl- , 2,2- Di methyl tetra hydro pyran-4-ol showed bioactivities like root colonization, antifungal, high salinity stress tolerance, production of secondary metabolites and agrochemicals, signalling of molecules, enhanced microbial tolerance, anti-oxidation, cryoprotection, immune response, regulating bacterial glycogen metabolism, gluconeogenesis, anti-inflammatory, plant defence mechanisms and promotes plant growth and metabolism
In earlier studies, Stenotrophomonas maltophilia UN1512 of strawberries reported the presence of Benzothiazole, 1,3,5,7-Cyclooctatetraene-1-carboxaldehyde, Carbonic Acid, octadecyl phenylester, Benzaldehyde,2,5-bis[(trimethylsilyl)oxy]-, Estragole, and Benzaldehyd , and significantly inhibited the growth of fungal pathogens and promote growth of tomato plants in vitro 43.
Volatile compounds like haloalkanetrichloromethane, 2,4-dimethyl heptane and 4-methyl octane, furans and dimethyl sulphide, α- and β-pinene, camphene, and Δ-3-carene were reported in S.rhizophila EP2.2 which are potential antifungal metabolites against A.alternata and B.cinerea18 ,44-47,49,50
Discussion
Currently, utilizing PGP bacteria in agriculture as Bio fertilizers and Bio inoculants is more winsome. Such bio inoculants protect plants from diseases and biotic and abiotic stress conditions by producing various regulatory chemicals, volatile organic compounds and secondary metabolites in the vicinity of the rhizosphere. Many Bacterial endophytes can colonize an ecological niche, making them potential biocontrol agents against diseases.
Phosphate solubilising endophytic bioinoculant is one of the alternative biotechnological solutions in sustainable agriculture to meet the phosphate demands of plants. IAA is one of the most crucial signal molecules in regulating plant growth. Salinity, pH and temperature are primordial abiotic factors which control plant growth, photosynthetic capacity, protein synthesis, energy, lipid metabolism, and total nitrogen content. PGP bacterial isolates which can have acclimatization to extreme high and low levels of salinity, pH and temperature will be a potential bioresource for sustainable crop productivity. In present research the isolate, Stenotrophomonas maltophilia AVSW 1, showed multiple potential by having acclimatization to abiotic factors apart from direct (IAA, phosphate solubilisation, Ammonia) and indirect (HCN, volatile compounds, siderophore s) mechanisms. Secondary metabolites such as 2- Pentanone, 4-Hydroxy-4-methyl, Cyclopropane,1-(1-Methyl ethyl)-2-Nonyl-, Glycine, N-Acetyl-N-(Trifluoro acetyl)-, Methyl Ester, 2-Acetoxy Iso butyryl Chloride, Propanoic Acid, 2-Oxo-, Methyl Ester, Pentanoic Acid, 4-Oxo-,5-Hydroxypentanehydroxylamine, Ethanol, 2-(Octyloxy)-, 2-Cyclopenten-1-One, 2-Hydroxy-3,4-Dimethyl-, 2,2- Di methyl tetrahydro pyran-4-ol present in AVSW 1 are reported to be responsible for root colonization and suppression of soil borne fungal pathogens. Hence tomato plants inoculated with AVSW1 showed enhanced growth in greenhouse trials. Further advanced technological intervention can be useful to bring potential formulation with this isolate Stenotrophomonas maltophila AVSW1.
Conclusion
In conclusion, Tomato plants inoculated with AVSW 1, an endophytic plant growth promoting bacteria isolated from chill roots effectively suppressed fungal (Fusarium oxysporum) growth and exhibited significant growth-promoting traits and growth enhancement compared to untreated control. In this study, PGP isolate AVSW 1 showed maximum PGP traits in in-vitro conditions, perhaps can be used as a plant growth promoter in several vegetable or fruit crops. AVSW 1 improves plant growth directly through phosphate solubilization, production of secondary metabolites, volatile organic compounds, and growth hormones including nitrogen fixation. It reduces phytopathogens by sequestration of iron, secretion of siderophores, release of volatiles, etc. Further, the growth of plant pathogens may be directly inhibited by antibiosis. AVSW 1 may also induce systemic resistance in the host, where the plant defence mechanism gets activated against pathogen attack. The results indicate that Plant growth-promoting rhizobacteria AVSW 1 isolated from chilli roots can help the tomato plant withstand stress and support the Plant morphologically, physiologically, and biochemically. It can potentially promote tomato growth directly or indirectly, and further exploration of AVSW 1 as a bioinoculant can be tested at the field level to confirm its commercial significance. Genomic, proteomic and meta bolomics of holobiome (Plant and associated micro biome) and interdisciplinary research findings of AVSW 1 will be beneficial to understand its biocontrol potential, mode of action, regulatory mechanisms, and plant-microbe interaction in detail.
Acknowledgement
The authors are thankful to the Acharya Nagarjuna Univeristy, Guntur, A.P for providing the well-equipped Laboratories along with required infrastructure to complete the study.
Funding Sources
Authors are thankful to the DST-FIST Instrumentation centre(DST-Delhi SR/FST/LS-1/620/2015) of Dept of Botany and Microbiology of Acharya Nagarjuna University, Guntur, Andhra Pradesh, India and the corresponding author thankful to University Grants commission for providing financial assistance of UGC-MRP (F.No 40-132/201(SR)).
Conflict of Interest
The authors declare that there is no conflict of interest
Data Availability Statement
This statement does not apply to this article.
Ethics Statement
This research did not involve human participants, animal, subjects, or any material that requires The ethical approval.
Informed Consent Statement
This study did not involve human participants, and therefore, informed consent was not required.
Authors’ Contribution
Gadala Swapna carried out the laboratory work, conceptualization, wrote the manuscript text and methodology. Amrutha V. Audipudi was the supervisor of the research work
References
- Alori E.T., and Babalola O.O. Microbial Inoculants For Improving Crop Quality and Human Health in Africa. Frontiers In Microbiology, 2018 ; 9:1-11.Doi.Org/10.3389/Fmicb.2018.02213
- Abdallah R.A.B., Khiareddine H.J., Nefzi A., and Remadi M.D. Evaluation of the Growth- Promoting Potential of Endophytic Bacteria Recovered from Healthy Tomato Plants. Journal Of Horticulture , 2018; 5(2): 1-10. Doi: 10.4172/2376- 0354.1000234
- Saikia B., Gogoi S., Ajit Kumar Savani A.K., and Bhattacharyya A. Metabolites and Peptides of Endophytic Origin in Plant Growth Promotion and Defence Reactions in Solanaceous Crop Tomato .New And Future Developments In Microbial Biotechnology And Bioengineering, 2022; 89-110. Doi.Org/10.1016/B978-0-323-85579-2.00005-8
- Adeleke B.S., Ayangbenro A.S., and Babalola O.O. Effect Of Endophytic Bacterium, Stenotrophomonas maltophilia JVB5 on Sunflowers . Plant Protectio Science ,2022; 58(3) :185-198. Doi: 10.17221/171/2021-PPS
CrossRef - Alexander A., Singh V.K., Mishra A., and Jha B. Plant Growth Promoting Rhizo Bacterium Stenotrophomonas maltophilia BJ01 Augments Endurance Against N2 Starvation By Modulating Physiology and Biochemical Activity of Arachis hypogea. 2019;14(9):1-20. Doi.Org/10.1371/Journal.Pone.0222405
- Singh R.P.and Jha P.N.The PGPR Stenotrophomonas maltophilia SBP-9 Augments Resistance Against Biotic and Abiotic Stress in Wheat Plants. Front Microbiol, 2017;8:1-15.Doi:10.3389/Fmicb.2017.01945
CrossRef - Kumar A., Singh V.K., Tripathi V., Singh P.S., and Singh A.K. Plant Growth-Promoting rhizobacteria (PGPR): Perspective in Agriculture Under Biotic and Abiotic Stress .Crop Improvement Through Microbial Biotechnology, 2018; 333- 342 Doi.Org/10.1016/B978-0-444-63987-5.00016-5
- Singh V. K., Singh A.K., Singh P.P., and Kumar A. Interaction of Plant Growth Promoting Bacteria With Tomato Under Abiotic Stress: A Review. Magriculture, Ecosystems & Environment, 2018; 267 : 129-140.Doi.Org/10.1016/J.Agee.2018.08.020
CrossRef - Alexander A.,Singh V.K., and Mishra A.Halotolerant PGPR Stenotrophomonas maltophilia BJ01 induces Salt Tolerance by Modulating Physiology And Biochemical Activities of Arachis hypogaea. Front microbiol , 2020;14 (9):1-20. Doi: 10.3389/Fmicb.2020.568289
CrossRef - Ulrich,K., Kube M.,Becker R.,Schneck V.,UlrichA. Genomic Analysis of the Endophytic Stenotrophomonas Strain 169 Reveals Features Related To Plant- Growth Promotion and Stress Tolerance:Sec.Microbe and Virus Interactions With Plants . Front. Microbiol., 2021;12:1-14 .Doi.Org/10.3389/Fmicb.2021.687463
- Osman N. H., and Ali A. Isolation, Identification And Evaluation of The Plant Growth Promoting Activities of Endophytic Stenotrophomonas maltophilia to Stimulate Growth of Clover Plants Under Salt Stress. Microbiology Research Journal International,2022 ; 32(8): 7-20. Doi: 10.9734/Mrji/2022/V32i81336
CrossRef - Aeron A., Dubey R.C., and Maheshwari D.K.Characterization of a Plant-Growth-Promoting Non-Nodulating endophytic Bacterium (Stenotrophomonas maltophilia) From the Root Nodules of Mucuna utilisVar. Capitata L.(Safed kaunch) . Canadian Journal Of Microbiology , 2020;66(11):1-9. Doi.Org/10.1139/Cjm-2020-0196
- Aktas C.,Ruzgar D., Gurkok S., and Gormez A.Purification and Characterization of Stenotrophomonas Maltophilia Chitinase With Antifungal and Insecticidal Properties. Preparative Biochemistry& Biotechnology,2022; 53(7): 797-806. Doi.Org/10.1080/ 10826068.2022.2142942
CrossRef - Quan C.,Wang X., and Fan S. Antifungal Compounds of Plant Growth Promoting Rhizobacteria and its Action Mode . Plant Growth And Health Promoting Bacteria, 2010;18:117-156. Doi: 10.1007/S11274-017-2364-9
CrossRef - Deshmukh S. K., Gupta M.K., PrakashV., And Saxena S. Endophytic Fungi: A Source of Potential Antifungal Compounds. Journal Of Fungi , 2018;4(3):77. Doi.Org/10.3390/Jof4030077
CrossRef - Ali S. Brilli ., Hameed S., Shahid M. Iqbal M.,Lazarovits G.,and Imran A. Functional Characterization of Potential PGPR Exhibiting Broad-Spectrum Antifungal Activity . Microbiol Res , 2020;232(126389) :1-1. Doi.Org/10.1016/J.Micres.2019.126389
CrossRef - Raio A., Brilli F., Neri L., Baraldi R., Orlando F., Pugliesi, Chen X., And Baccelli I. Stenotrophomonas rhizophila Ep2. 2 Inhibits Growth of Through the Emission of Volatile Organic Compounds, Botrytis Cinerea Restricts Leaf Infection And Primes Defence Genes. Frontiers In Plant Science, 2023;14:1-17. Doi:10.3389/Fpls.2023.1235669
CrossRef - Solís D.R., Salmón E. Z., Pérez M.C., Granados M.C.R., Rodríguez LM., and Santoyo G. Pseudomonas Stutzeri E25 and Stenotrophomonas maltophilia CR71 Endophytes Produce Antifungal Volatile Organic Compounds and Exhibit Additive Plant Growth-Promoting Effects. Biocatalysis And Agricultural Biotechnology , 2018;13:46-52. Doi.Org/10.1016/J.Bcab.2017.11.007.
- Alijani Z., Amini J., Ashengroph M., and Bahramnejad B.Volatile Compounds Mediated Effects of Stenotrophomonas maltophilia Strain UN1512 in Plant Growth Promotion and its Potential For the Biocontrol of Colletotrichum nymphaea . Physiological And Molecular Plant Pathology, 2020;112:1-13. Doi.Org/10.1016/J.Pmpp.2020.1015552020
- Hisatomi A.,Shiwa Y.,Fujita N., Koshino H.,Tanaka N.Identification and Structural Characterization of a Catecholate-Type Siderophore Produced By Stenotrophomonas maltophilia K279a .Microbiology Society, 2021; 167(7). Doi.Org/10.1099/Mic.0.00107
- Vacheron J.; Desbrosses G.; Bouffaud M.L.; Touraine B.; Moënne-Loccoz Y.; Muller D.; Legendre L.; Wisniewski-Dyé F.; Prigent-Combaret C. Plant Growth-Promoting Rhizobacteria and Root System Functioning. Frontiers In Plant Science, 2013;4: (356);1-19. Doi.Org/10.3389/Fpls.2013.00356
- Mahdi O., Eklund B., And Fisher N.Stenotrophomonas maltophilia: Laboratory Culture and Maintenance. Current Protocols In Microbiology , 2014 ;32:6F.1.1- 6F.1.6. Doi.Org/10.1002/9780471729259.Mc06f01s32
- Cochard B., Giroud B., Crovadore j.,Chablais R.,Arminjon L., and Lefort F., Endophytic PGPR From Tomato Roots: Isolation, In Vitro Characterization and InVivo Evaluation of Treated Tomatoes (Solanum lycopersicum L.) . Microorganisms, 2022;10(4),765. Doi.Org/10.3390/ Microorganisms10040765
- Kumar N.R.,V. Thirumalaiarasu., And P. Gunasekaran. Genotyping of Antifungal Compounds Producing Plant Growth-Promoting Rhizobacteria Pseudomonas Fluorescens. Current Science , 2002;82(12):1463-1466
CrossRef - Allu S., N. Pradeep Kumar, And Audipudi A.V. Isolation, Biochemical and PGP Characterization of Endophytic Pseudomonas aeruginosa Isolated From Chilli Red Fruit Antagonistic Against Chilli Anthracnose Disease. International Journal Of Current Microbiology And Applied Sciences, 2014; 3(2) : 318-329.
- Sarbadhikary S., And Mandal N.C. Field Application of Two Plant Growth Promoting Rhizobacteria With Potent Antifungal Properties. Rhizosphere , 2017;3(1). : 170-175. Doi.Org/10.1016/J.Rhisph. 2017.04.014.
CrossRef - Patten C.L., Glick B.R. Role of Pseudomonas putida indole-Acetic Acid in Developing the Host Plant Root System. Appl. Environ. Microbiol, 2002;68(8):3795-DOI: https://doi.org/10.1128/AEM.68.8.3795-3801.2002
CrossRef - Husen E. Screening of Soil Bacteria For Plant Growth-Promoting Activities in Vitro. Indones. J. Agric. Sci, 2003;4(1):27- 31. DOI:10.21082/Ijas.V4n1.2003.27-31
CrossRef - Aneja K. R. Experiments In Microbiology, Plant Pathology And Biotechnology. New Age International Publishers, India , 2007.
- Desire H.M., Bernard F., Forsah M.R., Assang C.T., And Denis O.N. Enzymes And Qualitative Phytochemical Screening of Endophytic Fungi Isolated From Lantana Camara Linn. Leaves. Journal of Applied Biology and Biotechnology , 2014; 2(6): 001-006. DOI: 10.7324/JABB.2014.2601
CrossRef - Maki L.M., Broere M., Leung, K.T., and Qin W. Characterization of Some Efficient Cellulase- Producing Bacteria Isolated From Paper Mill Sludges and Organic Fertilizers. Int J Biochem Mol Biol, 2011;2(2):146-154.
- Cappuccino J. G., And N. Sherman..Biochemical Activities of Microorganisms. Microbiology, A Laboratory Manual. The Benjamin/Cummings Publishing Co. California, USA, 1992: 188-247.
- Holt J.G., Krieg N.R., Sneath P.H.A., Staley J.T., And Williams S.T. Bergey’s Manual of Determinative Bacteriology, 9th Ed.Williams And Wilkins, Baltimore, USA.
- Saitou N., and Nei M.The Neighbour-Joining Method: A New Method For Reconstructing Phylogenetic Trees . Molecular Biology And Evolution, 1987;4(4): 406– 425. Doi.Org/10.1093/Oxfordjournals.Molbev.A040454
- Bhutto M.A., Dahot and M. Umar. Effect of Alternative Carbon and Nitrogen Sources on Production of Alpha-Amylase by Bacillus Megaterium. World Applied Sciences Journal (Special Issue Of Biotechnology & Genetic Engineering), 2010; 8(2): 85- 90. Doi:10.1016/J.Jbiotec.2008.07.1864
CrossRef - Maity J.P.,Kar S.,Lin C.L.,Chen Y.C.,Chang Y.C.,Jean S.J., and KulpT.K. Identification and Discrimination of Bacteria Using Fourier Transform Infrared Spectroscopy. Spectrochimica Acta Part A: Molecular And Biomolecular Spectroscopy, 2013;116:478-484.Doi.Org/10.1016/J.Saa.2013.07.062
CrossRef - Ramzan M., Raza A., Musharaff S.G.,UnNisa Z.Recent Studies On Advance Spectroscopic Techniques For Identifying Microorganisms: A Review. Arabian Journal Of Chemistry, 2023; 16 (3):104521.Doi.Org/10.1016/J.Arabjc.2022.104521.
CrossRef - Haron F.K., Shah M.D.,Yong Y.S., Tan J.K., Lal M.T.M., And Maran B.A.V. Antiparasitic Potential of Methanol Extract of Brown Alga Sargassum polycystum (Phaeophyceae) and its LC-MS/MS Metabolite Profiling. Diversity 2022; 14(10) 796; 1-12. Doi.Org/10.3390/D14100796
- Moldoveanu , S.C., and David V. Derivatization Methods in GC And GC/MS. Intechopen, 2018; DOI:10.5772/Intechopen.81954
CrossRef - Kumar N.P., and Audipudi, A.V. Exploration of a Novel Plant Growth Promoting Bacteria Stenotrophomonas maltophilia AVP 27 Isolated From the Chilli Rhizosphere Soil. International Journal Of Engineering Research And General Science ,2015;3(1): 265- 276; ISSN 2091-2730. http://Www.Pnrsolution.Org/Datacenter/Vol3/Issue1/34.Pdf
- Abdallah R.A.B.,Tlili S.M., Nfzi A.,Khiareddine H.J., and Remadi M,D. Biocontrol of Fusarium Wilt and Growth Promotion of Tomato Plants Using Endophytic Bacteria Isolated From Nicotiana glauca Organs. Biological Control, 2016;97 : 80-88. https://Doi.Org/10.1016 /J.Biocontrol.2016.03.005
CrossRef - Barthlomew D.C.,Banin L.F.,Bittencourt P.R.L.,Suis M.A.F.,Mercado L.M.,Nilus R. Burslem D.F.R.P., and Rowland L. Differential Nutrient Limitation and Tree Height Control Leaf Physiology, Supporting Niche Partitioning in Tropical Dipterocarp Forests Functional Ecology , 2022; 36:2084-2103. DOI:10.1111/1365-2435.14094
CrossRef - Alijani Z., Amini J., Ashengroph M., and Bahramnejad B. Volatile Compounds Mediated Effects of Stenotrophomonas maltophilia Strain UN1512 in Plant Growth Promotion and its Potential For The Biocontrol Of Colletotrichum Nymphaea. Physiological And Molecular Plant Pathology, 2020;112:101555 . Doi.Org/10.1016/J.Pmpp.2020.101555
CrossRef - Kai M., Effmert U., Berg G., Piechulla B. Volatiles of Bacterial Antagonists Inhibit Mycelial Growth of the Plant Pathogen Rhizoctonia solani. Arch. Microbiol, 2007;187(5) :351–360. Doi: 10.1007/S00203-006-0199-0 2007
CrossRef - Cernava T., Aschenbrenner I. A., Grube M., Liebminger S., Berg G. A Novel Assay For the Detection of Bioactive Volatiles Evaluated By Screening of Lichen Associated Bacteria. Front. Microbiol, 2015;6:398;1-9. Doi: 10.3389/Fmicb.2015.00398
CrossRef - Reyes-Perez J. J., Hernandez-Montiel L. G.,Vero S., Noa-Carrazana J. C., Quiñones- Aguilar E. E., Rincón- Enríquez G. Postharvest Biocontrol of Colletotrichum gloeosporioides on Mango Using the Marine Bacterium Stenotrophomonas rhizophila and its Possible Mechanisms of Action .J. Food Sci. Technol, 2019;56, 4992– 4999. Doi: 10.1007/S13197-019-03971-8
CrossRef - Rivas-Garcia T.,Murillo-Amador B., Nieto-Garibay A., Rincon-Enriquez G., Chiquito-Contreras R. G., Hernandez-Montiel L.G. Enhanced Biocontrol of Fruit Rot on Muskmelon By Combination Treatment With Marine Debaryomyces hansenii and Stenotrophomonas rhizophila and their Potential Modes of Action . Postharvest Biol. Technol, 2019: 151;61–67. Doi: 10.1016/J.Postharvbio.2019.01.013
CrossRef - Lin Y.T., Lee C.C.,Leu W.M.,Wu J.J., Huang Y.C., Meng M. Fungicidal Activity of Volatile Organic Compounds Emitted by Burkholderia gladioli Strain BBB-01. Molecules,2021 ;26(3):745: 1-15; Doi: 10.3390/molecules26030745
CrossRef - Baerlocher F.J., Langler R.F., Frederiksen M. U., Georges N. M.,Witherell R. D. Structure–Activity Relationships For Selected Sulfur-Rich Antifungal Compounds . Aust. J. Chem, 1999;52:167–172. Doi: 10.1071/C98141
CrossRef - Groenhagen U., Baumgartner R., Bailly A., Gardiner A., Eberl L., Schulz S. Production of Bioactive Volatiles By Different Burkholderia ambifaria Strains. J. Ecol, 2013; 39: 892–906. Doi: 10.1007/S10886-013-0315-Y
CrossRef - Wang C., Wang Z., Qiao X., Li Z., Li F., Chen M. Antifungal Activity of Volatile Organic Compounds From Streptomyces alboflavus TD-1. FEMS .Microbiol. Lett., 2013; 34(1): 45–51.Doi: 10.1111/1574-6968.12088
CrossRef - Li Q. L.,Ning P., Zheng L., Huang J. B., Li G. Q., Hsiang T. Fumigant Activity of Volatiles of Streptomyces globisporus JK-1 against Penicillium italicum on Citrus microcarpa . Postharvest Biol.Technol, 2010;58: 157–165. Doi:10.1016/J.Postharvbio.2010.06.003
CrossRef - Avalos M., Garbeva P., Vader L., Van Wezel G. P., Dickschat J. S., Ulanova D. Biosynthesis, Evolution And Ecology Of Microbial Terpenoids. Nat. Prod. Rep, 2022;39: 249–272. Doi: 10.1039/D1np00047k
CrossRef - Song C., Schmidt R., De Jager V., Krzyzanowska D., Jongedijk E., Cankar K. Exploring the Genomic Traits Of Fungus-Feeding Bacterial Genus Collimonas . BMC Genomics 2015:16:1103. Doi: 10.1186/S12864-015-2289-3
CrossRef